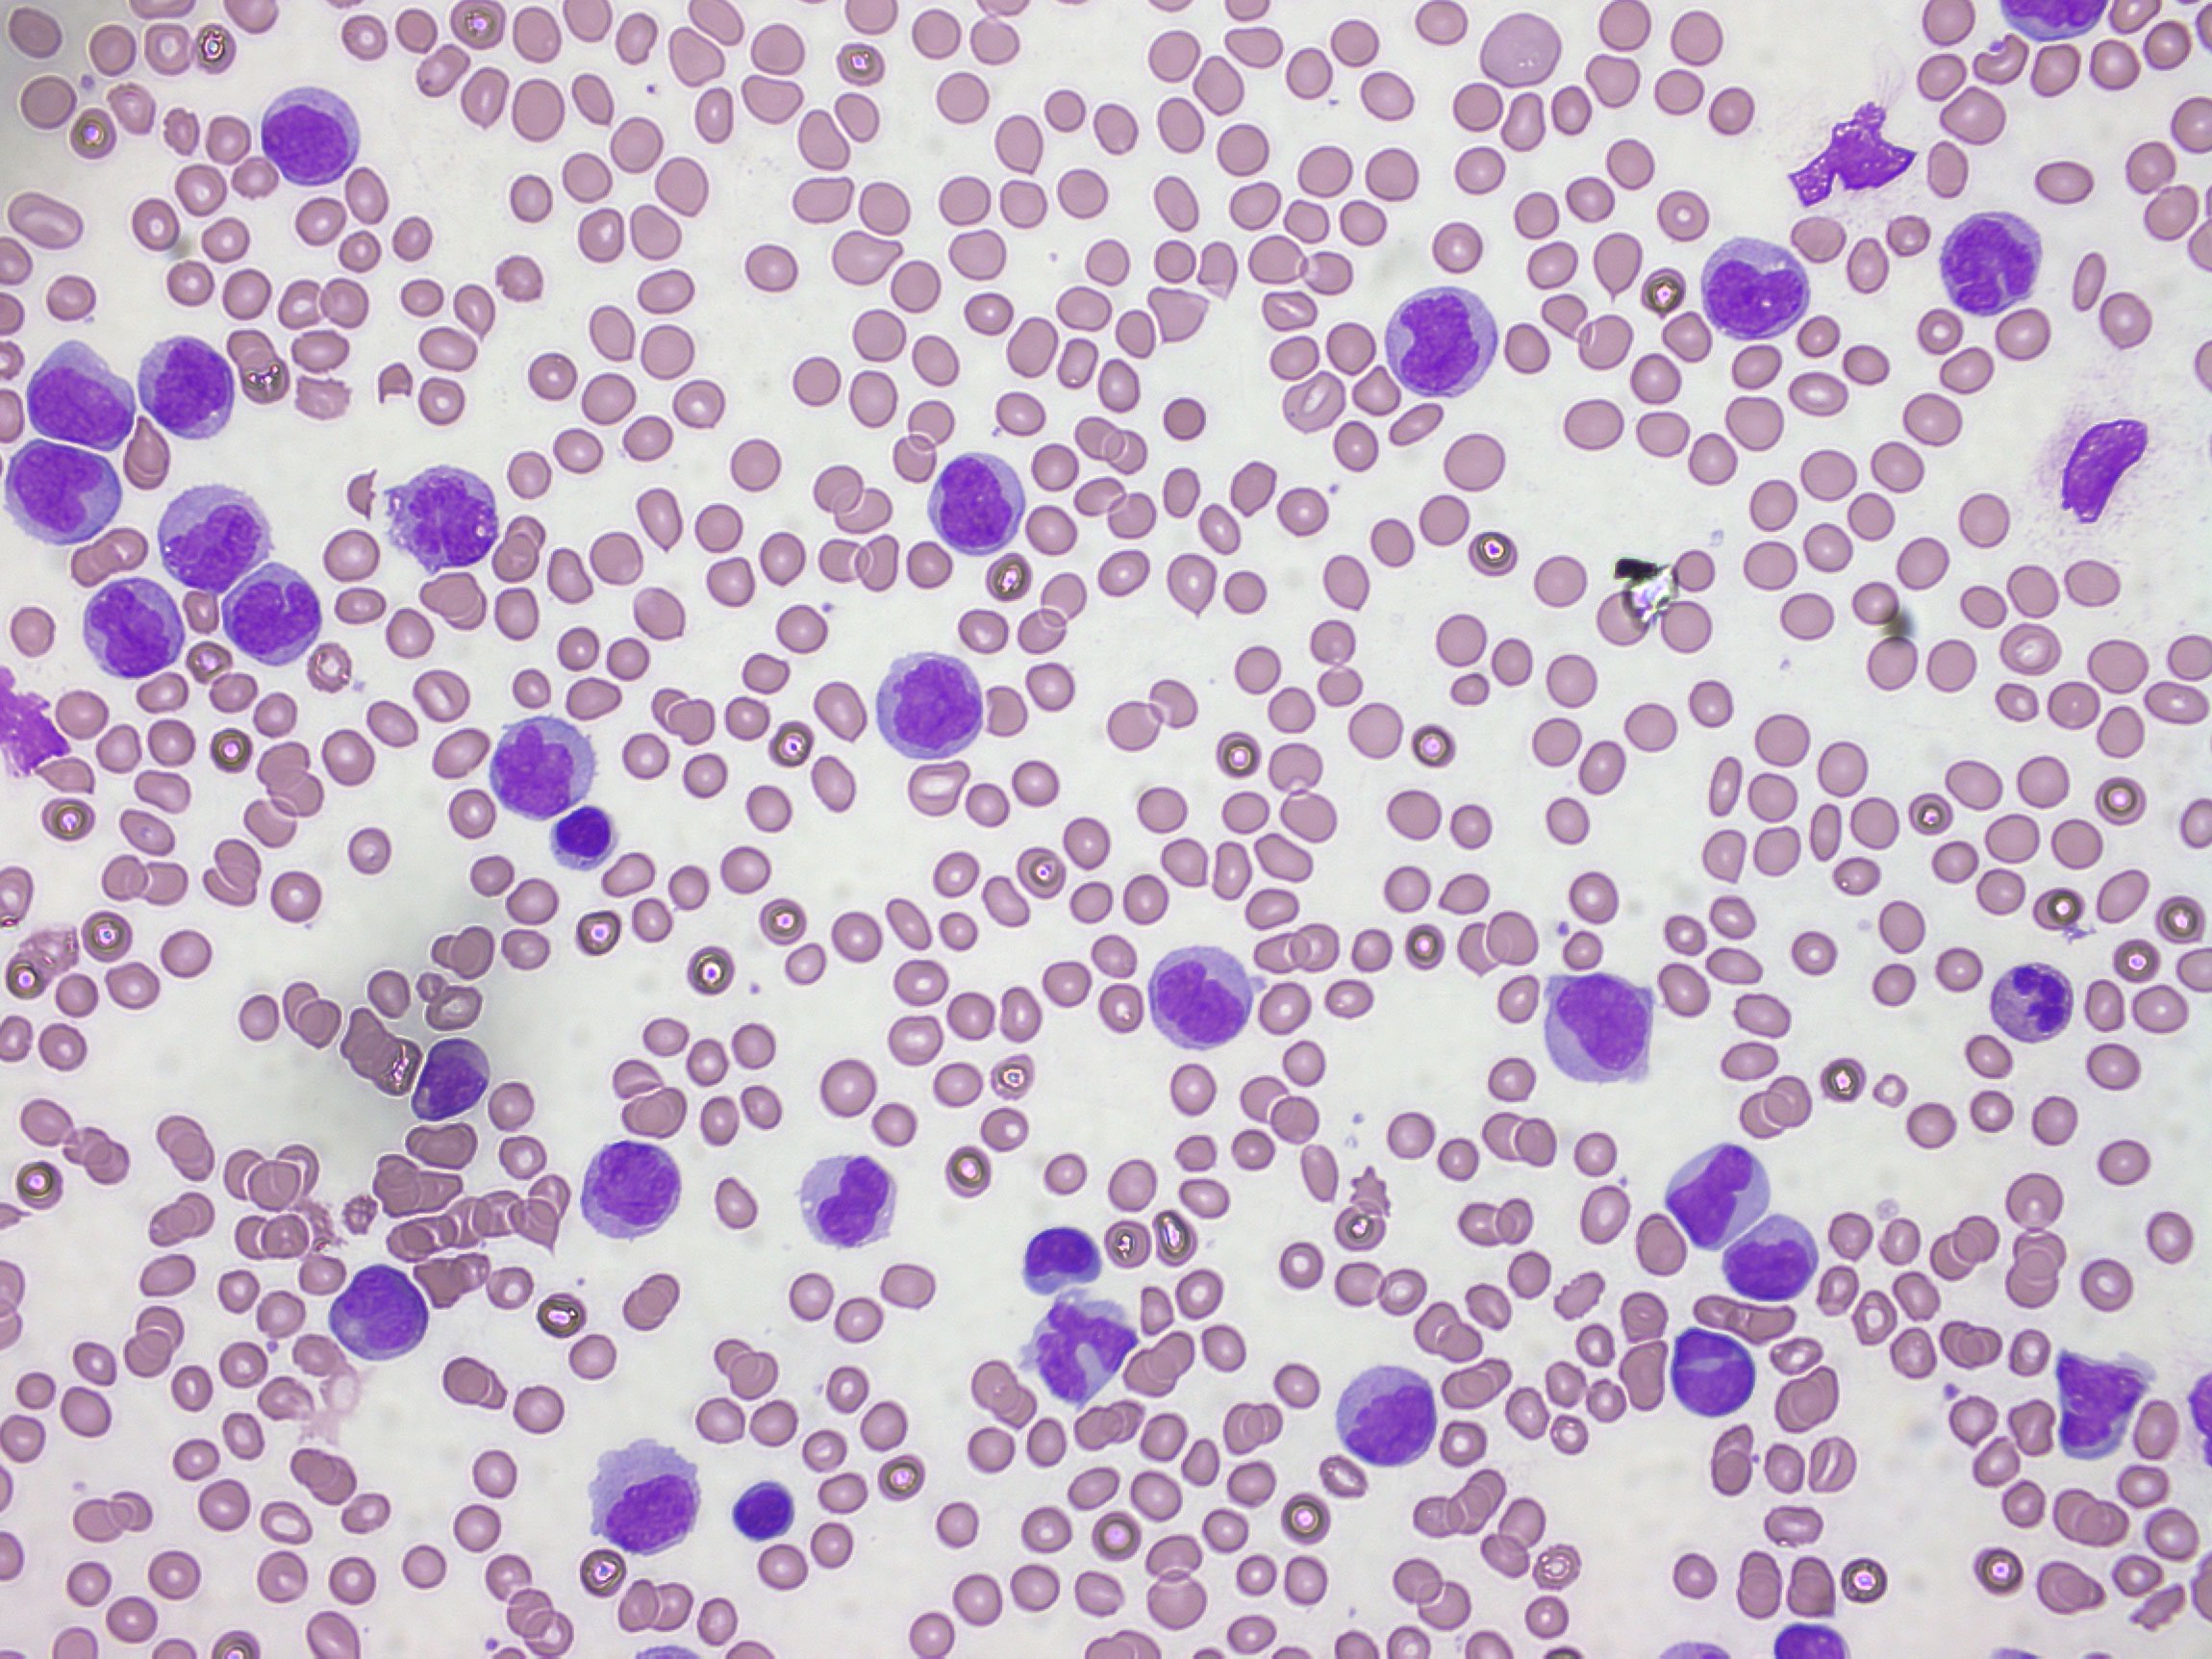
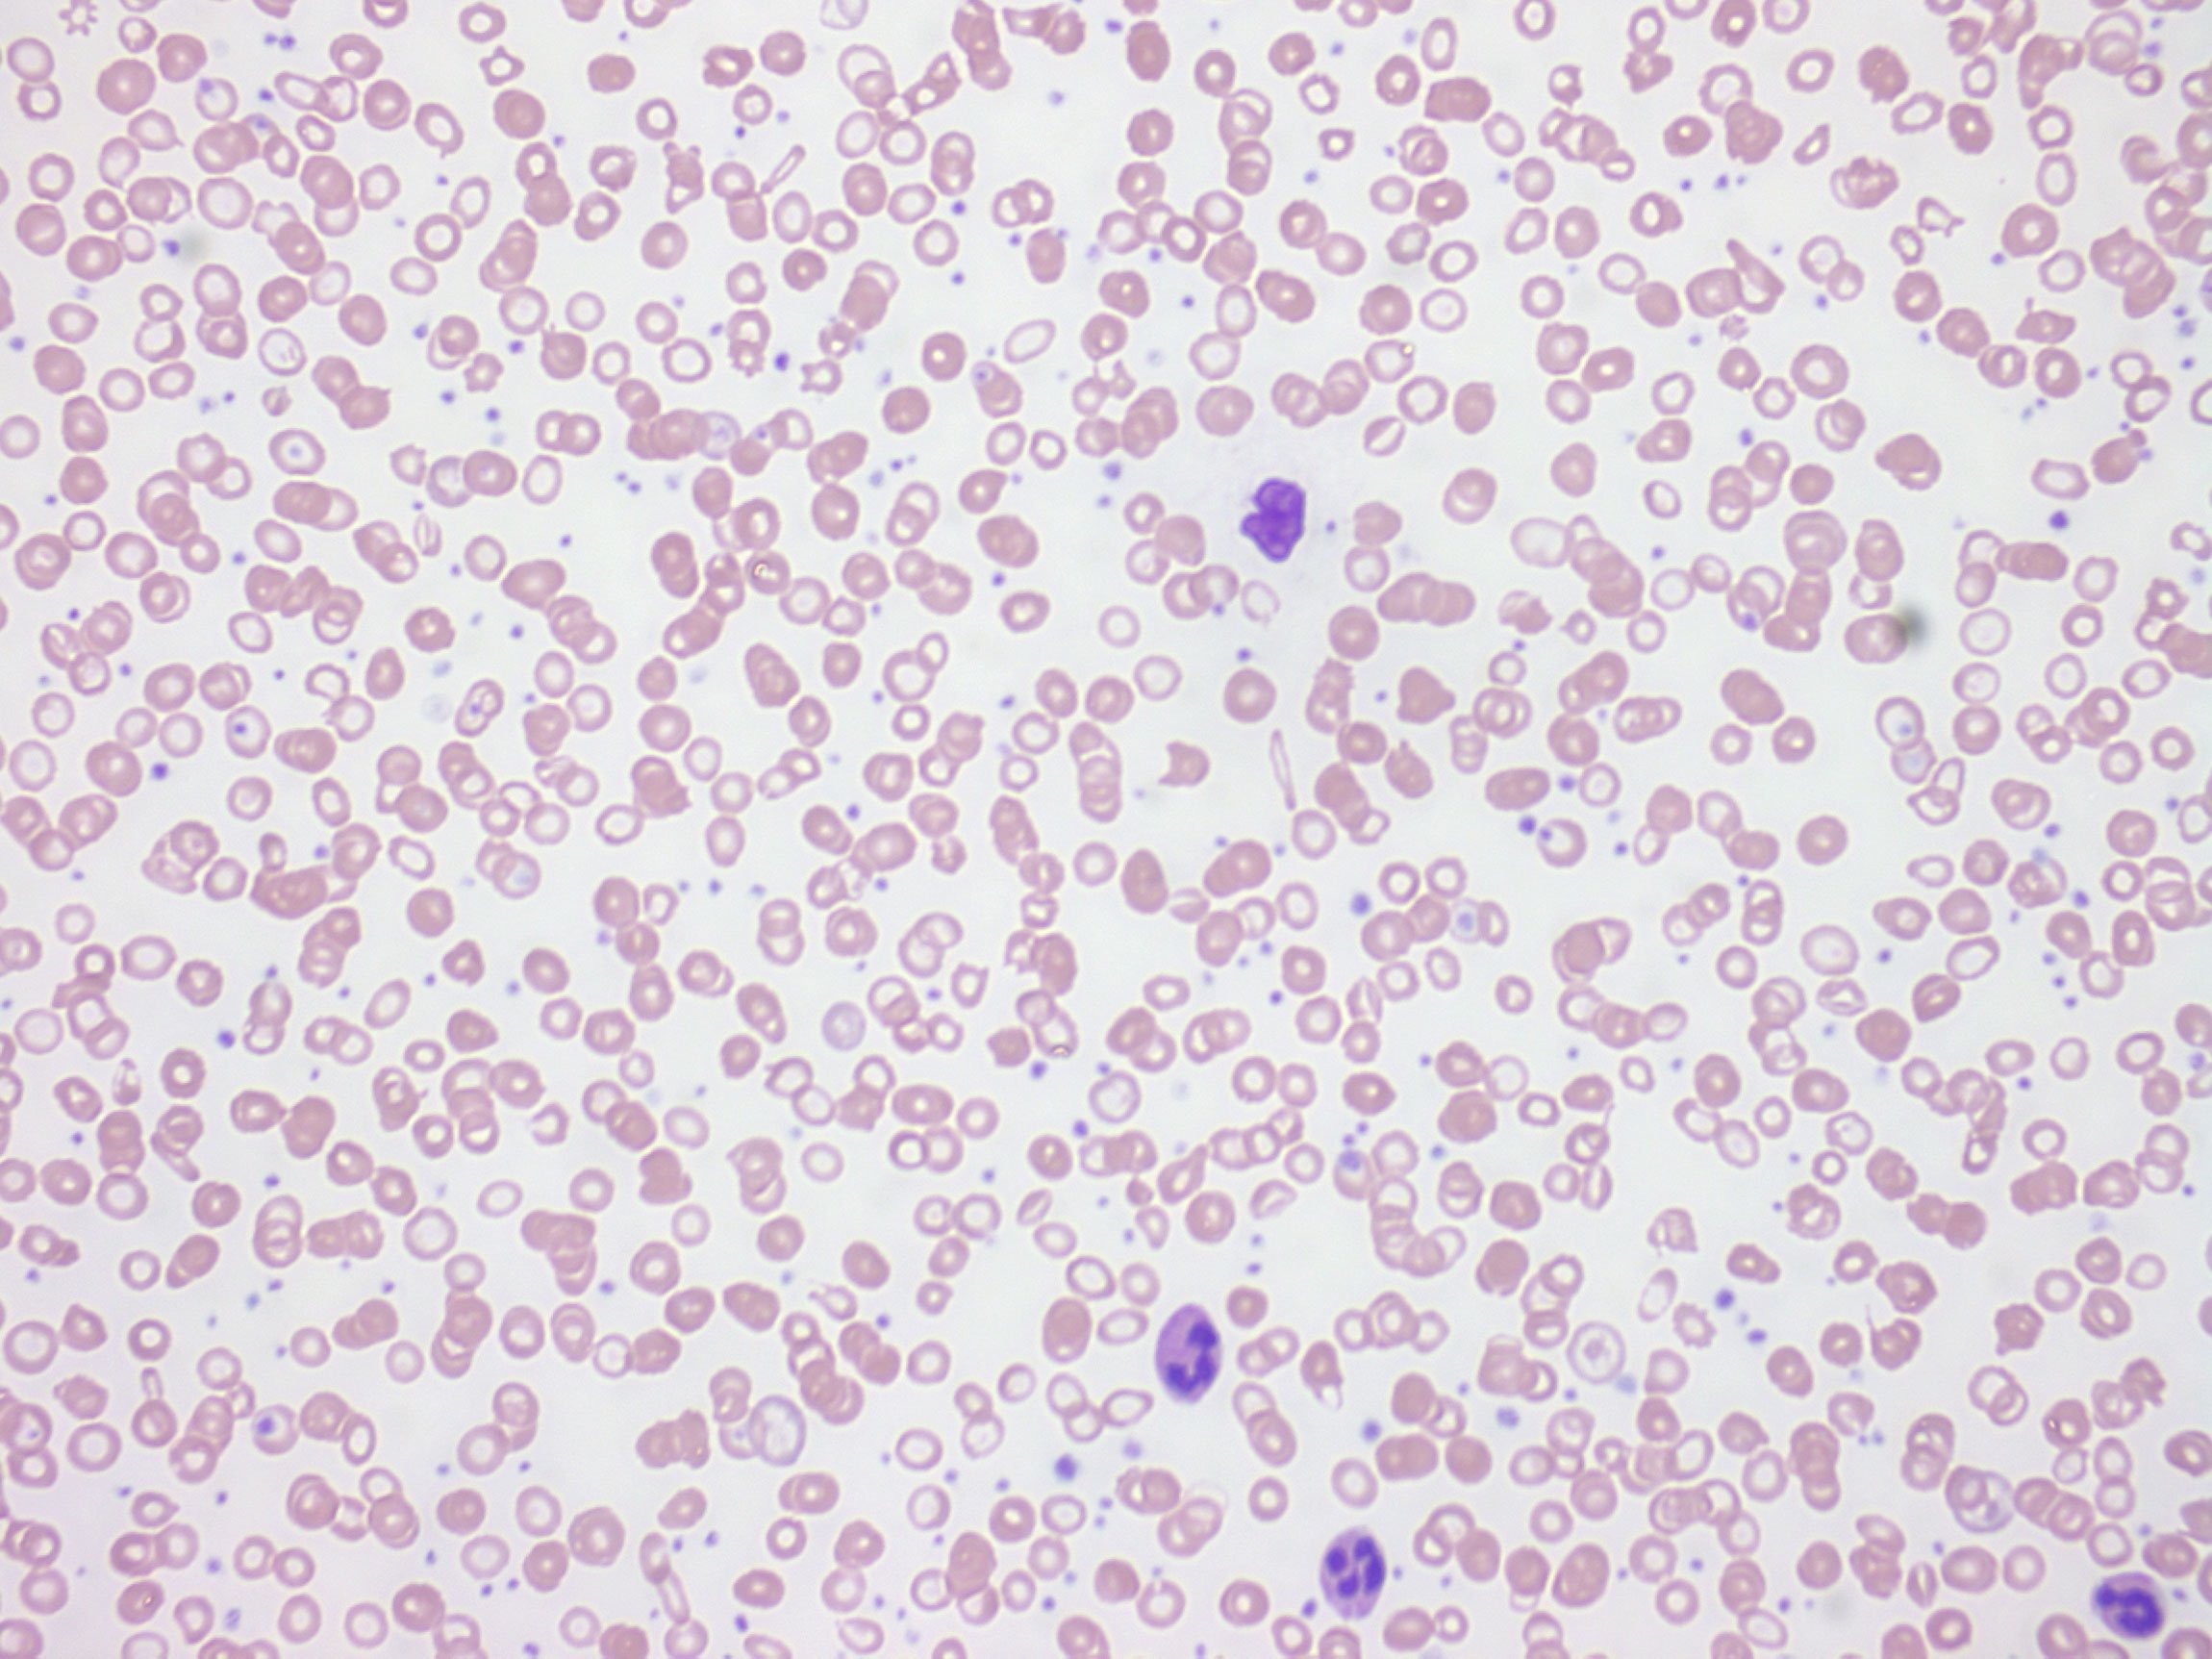

🔬 See the unseen in ultra HD – don’t get left behind!
The USB3.0 16.0MP Live Video Digital Microscope Camera by Luminoptic delivers professional-grade microscopy imaging with a high-resolution 16MP sensor and ultra-fast USB 3.0 interface. Compatible with a wide range of Windows and Mac systems, it features a universal C-Mount fitting and comes bundled with advanced ISCapture software for live video streaming and still image capture, making it an essential tool for precise scientific and industrial applications.
| Manufacturer | Luminoptic |
| Part number | DigiRetina16 |
| Item Weight | 890 g |
| Package Dimensions | 21 x 16 x 8 cm; 890 g |
| Material | PLA_(Polylactic_Acid), PC_(Polycarbonate), PE_(Polyethylene), PS_(Polystyrene), Plastic |
| Item Package Quantity | 1 |
| Batteries included? | No |
| Batteries Required? | No |
Trustpilot
2 days ago
1 month ago